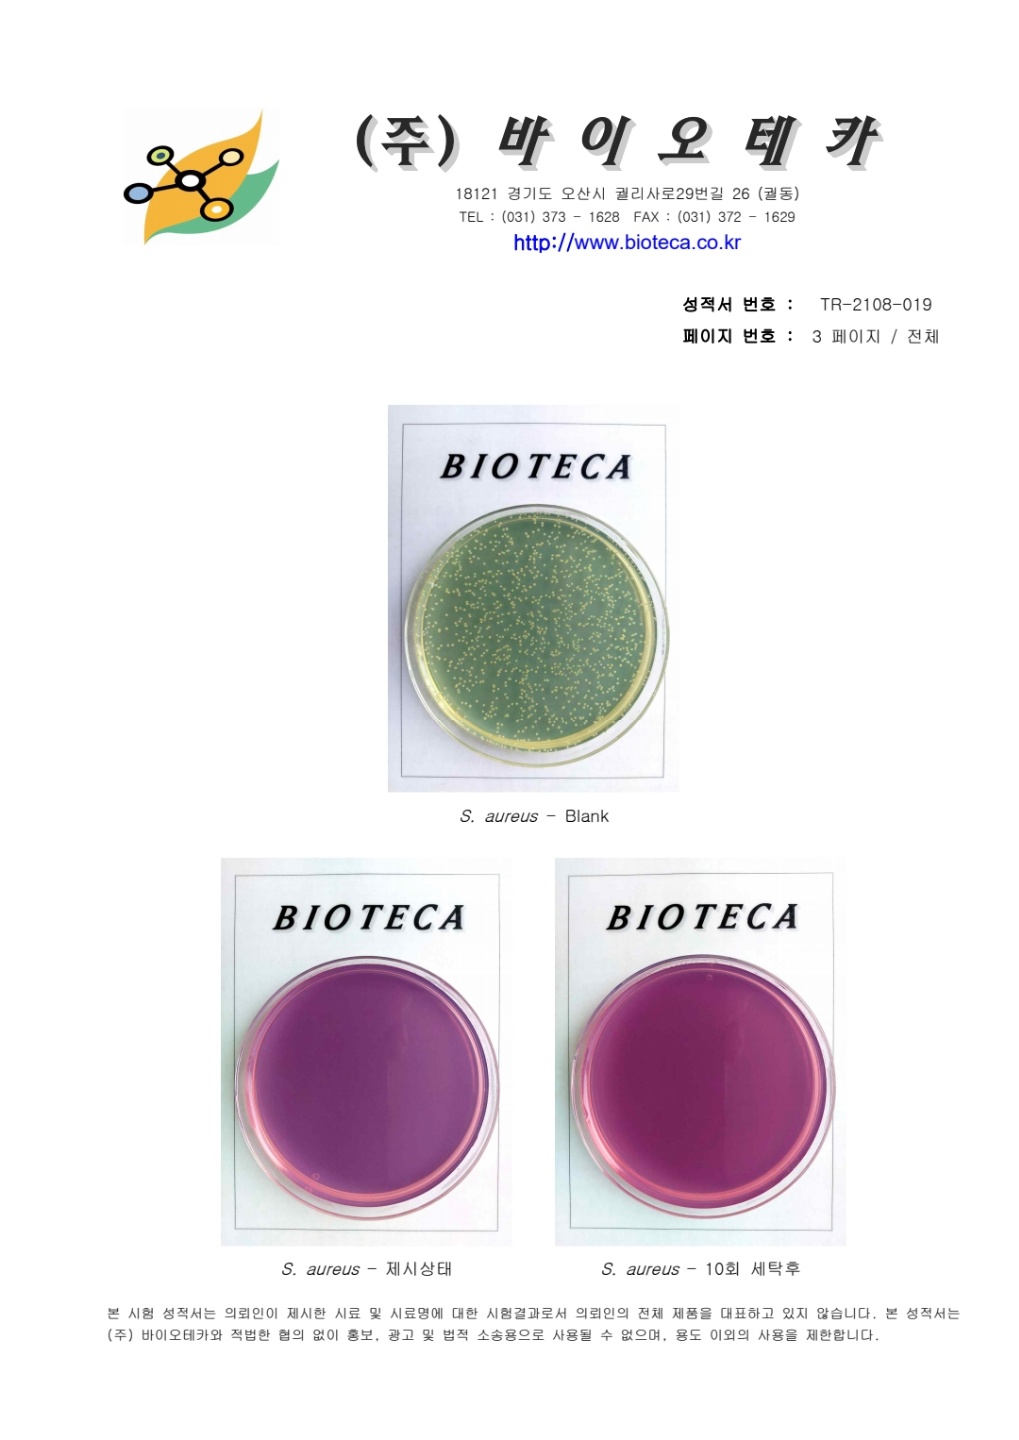

|
|
|

Recycle polyester 75d anti-bacterial solition 100% knit fabric
리사이클 항균사 시생산 했습니다.
- 시험균 : 황색포도상구균, 폐렴균
시험방법 : AATCC 100
. AATCC 100이 잘나오니 KSK 0693법은 더욱 잘 나올것 입니다.
|
|
|
|
고객의 새로운 미래를 창조하는 기업 |
|
에버텍스
|
주소: [41846] 대구 서구 달구벌대로 323길 99, 2층(중리동) / 전화: 010-3676-6941 / E-mail: songu6941@naver.com
Copyright ⓒ 에버텍스. All rights reseved. 관리
|
|
|